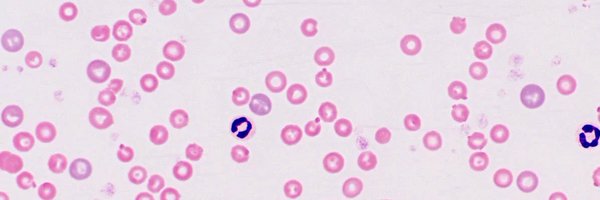
NickScelzi Profile Banner

Nick
@NickScelzi
Followers
16
Following
82
Media
1
Statuses
26
New Yorker | aspiring heme/onc doc | PGY3 DO, MBA | (Taylor’s Version)
Joined January 2022
Obviously unwinding before my interview this afternoon with a full listen of Midnights 🎶
0
0
0
Outstanding child neurology parent award goes to @DrYasminKhakoo. What a cool story, and well done, Aliya!
2
2
24
Been simultaneously studying for boards and preparing my ERAS applications has been .. not fun.
0
0
1
It’s dedicated time, which means i’ll consistently be grasping at any type of positive reinforcement with phrases like “Well if it was just the first 20 questions I would’ve gotten 20% higher!” and “This question doesn’t count since less than 50% got it correct.”
0
0
1
imagine callling “cowboy like me” a WEAK SPOT on evermore 🥱😮💨
📰| @EntInsider on @TaylorSwift13's "evermore" chances of winning AOTY "It contains more weak spots (Cowboy Like Me, Long Story Short, Closure). Despite the genius of 'Evermore,' a back-to-back victory for Swift would feel too partisan."
0
0
0
the saga continues, just thinking about the ‘chandelier / flicker in here’ rhyme scheme in death by a thousand cuts and that’s extent of my thoughts this afternoon
0
0
0
It’s happening again. I’m parked outside Starbucks, but I haven’t gone inside to study yet because all of Pure Heroine by Lorde has to play before I can take on any form of studying.
1
1
1
That I’m finishing up my third year and already stressing/anxious knowing that the next round of match will be for my class is a pretty decent reflection of the current state of medical education 🙃
0
0
1
One thing everyone should know about me is I can find something wrong with any EKG/image. Is it completely made up? Absolutely. But I found it nonetheless.
0
0
1
Alexa just started playing “right where you left me” completely unprompted. How can I expected to live, laugh, love (or god forbid do school work) under these conditions?
0
0
1
day 258 of third year, morale is low, havent anki’ed in months, haven’t activated my uworld subscription, 2 months out from STEP 2. send help (or ramen noodles)
0
0
1
I have to give a presentation for my ob/gyn rotation and i couldn’t help but pick a topic related to coagulopathy and DIC bc how do I pass up on that opportunity?
0
0
1
just worked a 24hr call. At the end of my shift I had to walk pretty far to my car, realized I lost my keys and had to retrace my steps, ultimately ordered an uber home, and had to get my car later on with my spare key. But God forbid students got free parking in the hospital lot
0
0
1
The disorientation from the 12 day stretch with two 24 hour calls in the mix is truly exquisite
0
0
0
In the span of a week I’ve seen a migrant mom-to-be become overwhelmed with joy at the sound of her baby’s heart after weeks of turmoil and no prenatal care and another mom experience DIC as her baby needed ventilation for meconium aspiration. Life is so delicate.
0
0
1
I was constantly hearing other people’s opinions on the different areas of medicine and letting their biases affect my thinking.
0
0
0
Before this, I would always reply to the question “What kind of specialty are you interested in” with “[Random specialty of interest at the time]…or maybe medicine and then heme/onc”. I said this because I had preconceived ideas about what it meant to practice in each specialty.
1
0
0